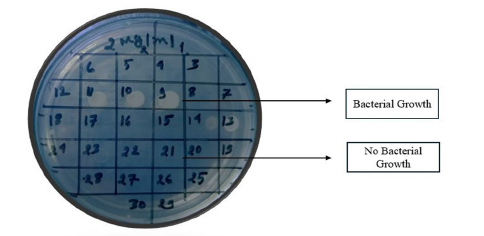

Mamun Al Asad1* and Zakia Sultana Katha2
1Department of Microbiology, Jahangirnagar University, Bangladesh
2Department of Applied Nutrition and Food Technology, Islamic University, Bangladesh
*Corresponding author: Mamun Al Asad, Department of Microbiology, Jahangirnagar University, Savar, Dhaka-1342, Bangladesh
Submission: November 18, 2024;Published: June 12, 2025
ISSN 2578-0190 Volume7 issues 4
Antibiotic Resistance (AR) is currently one of the biggest issues facing world health. AMR is a result of the abuse of antibiotics in the veterinary, healthcare, and agricultural fields. This involves improper prescription of antibiotics, overuse of antibiotics in the livestock industry, and inadequate sanitary practices in hospitals. Bacteria display a variety of defense strategies against antibiotics, and deciphering these defense mechanisms will be essential to resolving the current situation. It is possible to ascertain an isolate’s sensitivity or resistance to any therapy possibility using techniques based in laboratories for detecting antibiotic resistance. Antibiotic resistance can be minimized by the correct application of antimicrobial agents, immunization, research, creation of novel antibiotics, legislation, regulations, surveillance of antimicrobial resistance, and antibiotic use.
Keywords: Antibiotic resistance; Resistance mechanisms; Detection techniques; Controlling methods; Microorganisms
Antibiotics are employed for the treatment and avoidance of infections caused by bacteria. In the second part of the twentieth century, longevity increased substantially, largely due to the use of antibiotics. The employing of antibiotics in prophylaxis, meta-prophylaxis, infectious medication, and as a growth stimulant to increase feed effectiveness in sound livestock has revolutionized modern agriculture and livestock sectors [1]. Because antibiotics are either cytotoxic or cytostatic to microorganisms, they can be destroyed by the body’s own defenses, including the immune response. Most of our natural products, which are low molecular weight chemicals produced by microbes or derived from natural products, are effective against other microorganisms at low concentrations. However, certain antibiotics, such sulfa medications and oxazolidinones, are not derived from natural sources [2]. They frequently work by preventing the creation of proteins, Ribo Nucleic Acid (RNA), Deoxyribo Nucleic Acid (DNA), bacterial cells, membrane-disorganizing agents, or other particular processes [3]. The most important global health issue now is antibiotic resistance. Antibiotic resistance mechanisms are a typical result of the overuse of antibiotics in both farming and medicine. These mechanisms pose a threat to modern medicine by reducing the effectiveness of therapeutically important medications. Morbidity and death from treatment failures as well as higher health care expenses have been brought on by resistance to Anti-Microbial Drugs (AMR) [4]. In the past, antimicrobials were mostly chosen by veterinarians based on their clinical observations while treating bacterial infectious illnesses. However, it is now more challenging for doctors to empirically choose an effective antimicrobial drug due to the rise in bacterial resistance to antimicrobials that were once widely utilized [5]. A century of advancements in health care outcomes are at risk due to the growing threat of Anti-Microbial Resistance (AMR) across the world. It puts at risk the safety of food and current veterinary and human medicine [6]. Because they check specifically for bacterial growth on solid or liquid medium in the presence of antibiotics, conventional methods for phenotypic antibiotic susceptibility tests are still vital in routine diagnostics. The disc diffusion assay and E-test are examples of solid medium based antibiotic susceptibility assays that require at least 18 to 22 hours for the bacteria to develop noticeably on agar plates in order to assess growth inhibition visually [7]. One way to look at the existence of an antibiotic resistance gene is by molecular analysis [8]. Antibiotic resistance can be reduced to a considerable extent through proper application of antimicrobial agents, vaccination, research, education, the creation of novel antibiotics, policy, legislation, monitoring of resistance to antibiotics, and antibiotic use [9]. Therefore, the review’s goal is to examine antibiotic resistance mechanisms, detection techniques, and management approaches.
Anti-Microbial Resistance (AMR) represents a significant public health issue. It describes how microorganisms, including bacteria, viruses, parasites, and fungi, can become resistant to medications or other antimicrobial agents that are meant to either kill them or stop them from growing. Antibiotics, antivirals, antifungals, and antiparasitic medicines are among these. Drug resistance in microorganisms can result in treatment failures, higher healthcare expenses, longer sickness durations, and occasionally even death [10]. AMR is a complicated problem that affects the entire world. AMR has been linked to the abuse of antibiotics in the veterinary, medical, and agricultural fields. This includes improper prescription of antibiotics, overuse of antibiotics in the livestock industry, and inadequate hygienic practices in hospitals. The spread is also being accelerated by international travel and trade. Microorganisms are now able to outpace the creation of new medications since the pipeline for developing new antibiotics has slowed, mostly because there are not enough incentives. The evolution of modern medicine was made possible by the discovery of antibiotics, which made surgical treatments safer and allowed for the cure of formerly fatal infections [11]. When microorganisms no longer show inhibition from an antibiotic to which they were previously sensitive, they are referred to be “antimicrobial-resistant” or “drug-resistant.” Resistance genes contained in the microbe’s DNA encode this type of resistance, which is known as acquired resistance. While some resistance genes have developed over many years because of natural selection by naturally occurring antimicrobials in the environment, others can arise spontaneously through changes in microbial DNA. These genes could spread drug resistance from drug-resistant to drug-sensitive bacteria. Just four years after the widespread use of penicillin as a treatment was established, in the late 1940s, the first drug-resistant bacteria in a clinical setting were discovered. Subsequently, the proliferation and dispersion of microorganisms resistant to drugs have escalated. A significant portion of hospitalacquired infections are caused by highly resistant bacteria, such as vancomycin-resistant enterococci and Methicillin-Resistant Staphylococcus Aurous (MRSA) [12].
The different methods by which bacteria might become resistant to antibiotics and other antimicrobial treatments are referred to as “bacterial resistance mechanisms.” These mechanisms are of great concern in contemporary medicine because they may result in decreased antibiotic efficacy and more difficult-to-treat bacterial infections. Bacteria can develop resistance through several mechanisms, including: Genetic mutation, Target modification, Efflux pumps, Enzymatic degradation, Biofilm formation, Horizontal gene transfer, Reduced permeability and others [13,14].
Genetic mutation
Figure 1:A schematic illustrating how mutations cause antibiotics to lose their ability to attach to their intended
target.
a. A bacterium of wild type.
b. Antibiotics that attach to the intended bacterial target and kill it.
c. The target wild-type bacteria can bind to the antibiotic and be destroyed.
d. Following a mutation, the binding site is changed, making it impossible for the antibiotic to attach to the
mutant bacteria and destroy it. These bacteria will multiply and form a new, resilient colony [14,17].

DNA mutations that affect bacterial targets within the cell, including proteins or enzymes those drugs would typically inhibit can occur in bacteria (Figure 1). The antibiotics’ ability to combat the altered bacterium is diminished by this modification. A spontaneous alteration in a gene’s DNA sequence, known as a mutation, can alter the trait for which the gene codes [15]. A change in one base pair may result in a change in one or more of the amino acids that it codes for. This alteration in the enzyme or cell structure might subsequently affect the targeted antimicrobials’ affinity or efficacy. Base changes brought about by external agents, DNA polymerase errors, deletions, insertions, and duplications in bacterial genomes are frequently the causes of mutations [16,17].
Target modification
Antibiotic-interacting target sites are subject to structural or functional modifications by bacteria. To make it more difficult for antibiotics to interact with these structures, bacteria can, for example, alter the structure of their ribosomes or cell walls. The staphylococcal mechanism of changing the Penicillin Binding Protein (PBP), which is the target of β-lactam antibiotics, is a classic example of drug target modification [18].
Efflux pumps
Proteins known as efflux pumps are transporters that help move harmful materials out of cells and into the surrounding environment. An extensive range of antibiotics are extruded to the outside of bacteria by efflux pumps, which are important agents in the development of drug resistance in bacteria (Figure 2), [19]. Therefore, infections brought on by these organisms may be challenging to cure [15]. While certain efflux pumps can only move one drug at a time, others may move several substrates at once. The five main efflux pumps are as follows. families: Resistance Nodulation Cell Division Subfamily (RND), ATP Binding Cassette (ABC) family, Major Facilitator Superfamily (MFS), Small Multidrug Regulator Subfamily (SMR), and Multidrug and Toxic Effects (MATE) family. Efflux pump genes can be acquired or innate. A mutation in a regulatory gene or environmental cues might trigger the chromosomally encoded intrinsic efflux mechanism of resistance [20].
Figure 2:Bacterial efflux system: A) Antibiotic interfering with protein production by ribosomes. B) Antibiotic interfering with protein production by ribosomes [19,17].

Horizontal gene transfer
Bacteria can pick up resistance genes from their neighbours through the genetic material exchange they do with one another. DNA can be transferred directly through conjugation, transformed by phages or viruses, or transferred indirectly through transduction. The quick distribution of resistance is facilitated by this important technique [21].
Biofilm formation
Biofilms are complicated microbial colonies made up of fungus and bacteria. A protective matrix that the microorganisms create and secrete keeps the biofilm securely adhered to either a living or non-living surface. Bacteria trapped in a thick, slimy layer of proteins and carbohydrates are known as biofilm. The microbes are shielded from outside hazards by the biofilm barrier. The absolute number of resistant mutants that can be selected under antimicrobial pressure is increased by the high cell density in biofilms [22].
Enzymatic degradation
Antibiotic resistance in bacteria is primarily mediated by the enzymatic breakdown of the antimicrobial agent. Enzymes that degrade or alter antibiotics can be produced by bacteria, making them less effective. Antibiotics can be rendered inactive by certain bacterial enzymes. For instance, penicillin and other beta-lactam antibiotics can be rendered useless by the breakdown of these drugs by beta-lactamase enzymes [23].
Inactivation of drugs
Bacteria can inactivate drugs by either removing a chemical group from the drug directly or transferring it to another chemical group. For instance, β-lactamases are enzymes that can break down drugs as part of the inactivation process. Tetracycline is another example, which can be inactivated by the tetX gene [24]. Drug inactivation through chemical group transfer usually involves adding adenyl or acetyl groups to the drug, and several enzymes that facilitate this transfer have been identified. Aminoglycosides are drugs that undergo adenylation and phosphorylation, with acetylation being the most common method used to modify these and other substances [24,25].
Quorum sensing
Many microorganisms, including bacteria, use a fascinating communication mechanism called quorum sensing to coordinate group actions according to population density. It is an essential mechanism that controls the expression of genes and is involved in many biological processes in both pathogenic and helpful microbes. When certain bacteria reach a particular density in their population, they use quorum sensing to coordinate the production of resistance genes. They are able to defend themselves against antibiotics as a group as a result [26].
Survival strategies and piggyback resistance
Bacteria can enter a dormant or non-replicating state, making them less susceptible to antibiotics that target actively dividing cells. This is especially typical when it comes to tuberculosiscausing Mycobacterium tuberculosis. Additionally, bacteria may occasionally become resistant to one antibiotic, which can lead to cross-resistance to additional medicines that have comparable modes of action [27].
Antimicrobial resistance in individual bacterial isolates is found by in vitro processes known as antimicrobial susceptibility testing methods. The sensitivity or resistance of isolation to any therapy candidate can be ascertained using those laboratorybased detection techniques. The establishment and dissemination of resistant bacteria among the population can also be tracked using those techniques [28]. Various global organizations regularly update their guidelines and recommendations on this subject. The CLSI in the USA, the OIE in the EU, and CDS-AST in Australia are some of the organizations that provide information on antimicrobial testing procedures and interpretive standards for veterinary infections [29]. The two most often utilized tests in veterinary laboratories are the broth micro dilution method and the agar diskdiffusion method. The dilution method (broth and agar dilution method), disk-diffusion method, E-test, automated approaches, and genotypic methods are a few instances of antibiotic sensitivity testing techniques [30].
Disc diffusion is the process of applying commercially available drug-impregnated filter paper discs to the surface of an agar plate that has been injected to confluence with the target organism [31]. The Kirby-Bauer antibiotic test is another name for disc diffusion. The medication diffuses radially through the agar, with its concentration dropping logarithmically as the distance from the disc increases. This causes a growth inhibition zone to form around the disc, the diameter of which is inversely proportional to the MIC. The organisms are described as susceptible, intermediate, or resistant, and the zone diameters are interpreted using the recommendations that CLSI has provided. Only quickly developing organisms-for which zone size interpretation criteria are available-can be tested using disc diffusion. The Minimum Inhibitory Concentration (MIC) for that specific bacterial strain is correlated with the diameter of the zone of inhibition surrounding the antimicrobial disc; the zone of inhibition and the test bacterium’s MIC have an inverse relationship. Generally speaking, the bigger the zone of inhibition, the less antibiotic dose is needed to stop the organisms from growing [32]. The Minimum Inhibitory Concentration (MIC) for that specific bacterial strain is correlated with the diameter of the zone of inhibition surrounding the antimicrobial disc; the zone of inhibition and the test bacterium’s MIC have an inverse relationship. Generally speaking, the bigger the zone of inhibition, the less antibiotic dose is needed to stop the organisms from growing [5]. To conduct a disc diffusion test, a large (150mm diameter) Mueller-Hinton agar plate is coated with a bacterial inoculum of roughly 1-2×108CFU/ ml. Every antibiotic disk’s surrounding zone of growth inhibition is measured to the closest milli meter. The medication’s diffusion rate through the agar medium and the isolate’s susceptibility are shown by the zone’s diameter. Based on guidelines published by the Clinical and Laboratory Standards Institute (CLSI0), the zone widths of each medical treatment are interpreted. As a type of susceptibility (i.e., susceptible, intermediate, or resistant) (Figure 3) rather than a Minimum Inhibitory Concentration (MIC) is obtained from the disc diffusion test, the results are “qualitative” [28]. Not expensive equipment is needed, and the test is simple to conduct and reproducible. Measured with calipers or a ruler, the diameter of the zone of growth inhibition is recorded in millimeters [33].
Figure 3:Antibiotic susceptibility test: Disc diffusion methods.

Dilution techniques are yet other essential assays for determining a bacteria’s antibiotic sensitivity. The lowest concentration of an antibiotic that inhibits bacterial growth is known as the Minimum Inhibitory Concentration (MIC), and dilution procedures provide quantitative information on this value in contrast to disc diffusion tests, which only yield qualitative results [30].
Broth dilution technique
Using the broth dilution approach, the isolate is exposed to a range of antimicrobial agent concentrations in a broth-like medium. Micro dilution testing can be easily carried out in a micro titer format and requires 0.05 to 0.1ml of total broth volume. Standard test tubes are filled with broth at a volume of roughly 1.0ml for macro dilution testing. The least inhibitory concentration, or MIC, for each broth dilution procedure is the lowest concentration at which the isolate is totally inhibited (Figure 4), [34] Therefore, the lowest concentration of the antibiotic that will prevent this isolation is known as the minimum inhibitory concentration, or MIC. The Minimal Inhibitory Concentration (MIC) approach is another name for the broth dilution method of testing for antibiotic susceptibility. A set volume of nutrient broth with a standard concentration of bacteria is added to test tubes or wells holding escalating quantities of each antibiotic to be tested, ranging from 0.0312 to 512μg/ml. Every tube contains twice as much antibiotic as the one before it [34]. A culture tube containing non-selective broth medium is filled with an antibiotic at various doses for the broth dilution assay [17]. For 16 to 20 hours, tubes are incubated in ideal conditions for the test microorganism. Spectrophotometry or plating counts are two methods that can be used to measure the antimicrobial action [35].
Figure 4:Diagram broth dilution methods [34].

Agar dilution technique
There are several agar plates made for the agar dilution procedure. Typically, gradients or dilution series are used to incorporate the antibiotic’s various concentrations into the agar. A uniform bacterial suspension is either spot- or streak-injected onto the agar plates. After that, the plates are incubated in a suitable environment. Monitoring is made for bacterial growth on the plates after incubation. The lowest concentration of antibiotic that stops bacterial growth on agar from being visible is the minimum inhibitory concentration, or MIC (Figure 5), [35]. Most nonfastidious organisms grow satisfactorily and reproducible results are two benefits of using agar dilution testing. Routine clinical laboratories rarely use agar dilution testing, but research labs or regional reference laboratories that need to screen a lot of isolates may find it useful [34].
Figure 5:Diagram agar dilution methods.
A quantitative method of testing for antimicrobial sensitivity, the Epsilometer Test (sometimes called the E-test) is used to find the Minimum Inhibitory Concentration (MIC) of antibiotics against bacteria. Because it offers accurate assessment of an organism’s susceptibility to antibiotics, it is a useful tool in clinical microbiology and research. The antimicrobial concentration gradient in an agar plate serves as the foundation for the E test method’s theory (Figure 6), [31]. These strips have a concentration scale labelled on the upper surface and an impregnated dried antibiotic concentration gradient on the underside. The drug released instantly when this E test strip was placed onto an agar plate that had been contaminated. For picky organisms such S. pneumoniae, ß-hemolytic streptococci, N. gonorrhoeae, Haemophilus species, and anaerobes, the E test has been used to determine MIC. When compared to the disc diffusion approach, the E test is slightly more expensive. However, the Minimum Inhibitory Concentration (MIC) of antifungal and antimycobacterial drugs can also be found using the straightforward, accurate, and dependable E test [36].
Figure 6:E test gradient diffusion method.

Many automated methods that are sold commercially can assist cut down on the duration of technical time needed to conduct and document regular sensitivity testing. For instance, a camera that is interfaced to a computer system can be used to read the results of disc sensitivity tests and breakpoint sensitivity testing. Other Systems monitor turbidity (nephelometry) or CO2 production to determine how antibiotics affect the pace of bacterial growth. These systems make use of liquid cultures. The required incubation period can be greatly reduced by using these automated methods [37]. There are various kinds of automated equipment, including the Vitek 1 and 2, BD Phoenix, Trek Sensititere, and Micro Scan Walk Away. Increased reproducibility, lower labour costs, and quick answers are some benefits of employing this test; nevertheless, their limited availability in developing nations, such as the nation of Africa, is a drawback [17].
In many clinical investigations concerning bacterial infections, whether in humans or animals, molecular characterization of the genetic mechanism(s) underlying a given phenotypic result obtained by conventional antibiotic sensitivity testing is now an essential component. Sometimes it is possible to determine whether a gene is present using molecular analysis if phenotypic results are too laborious, inconclusive, or unavailable. Research and reference laboratories both employ molecular approaches extensively. While modern techniques like Whole-Genome Sequencing (WGS) and Matrix-Assisted Laser Desorption Ionization-Time of Flight Mass Spectrometry (MALDITOF MS) are just getting started, some of the procedures used, such PCR and hybridization techniques, have been around for decades [8].
Similar to other bacteria, antibiotic-resistant microorganisms proliferate throughout the world. This implies that they can spread across our surroundings and be passed from person to person, animal to food, and so on. Because of these connections among the many industries, fighting antibiotic resistance requires a multifaceted approach. Antibiotic resistance must be slowed down and the useful lifetime of effective antibiotics must be extended by appropriate usage in medical, animal health, and agricultural settings. Due to antibiotic resistance and a dearth of novel medications, the state of antibiotic treatment for bacterial infections has steadily gotten worse. Reducing prescriptions is one of the most efficient methods to lessen selection pressure, since it appears that it is now evident that the use of antibiotics might promote the formation of antibiotic-resistant bacteria [38]. Rapid transmission makes resistant bacteria a reservoir of bacteria that can infect humans and other animals. Because of resistant bacteria, animals might have infections that are hard to cure, which results in pain for the animals as well as financial losses.
A formalized, workable guideline for optimal antibiotic prescribing should be developed and followed by formulary implementation of the guidelines in order to avoid antibiotic overuse and misuse. Current management measures can be enhanced by the development of rapid and efficient molecular diagnostic techniques for the detection and epidemiological surveillance of antibioticresistant bacteria’ resistance genes. Using fewer antibiotics in agriculture is crucial, especially when it comes to food animals. Introducing financial incentives for the development of livestockspecific antibiotics, enforcing stricter drug licensing regulations, imposing penalties, and banning or restricting the use of veterinaryimportant medicines are some of the policy changes pertaining to the use of antibiotics in livestock. Antibiotic resistance is a problem that requires effective solutions. Antibiotic resistance can therefore be minimized by the proper use of antibiotics, immunization, education, research, and creation of novel antibiotics, legislation, regulations, surveillance of antimicrobial resistance, and the use of antibiotics [3,39].
Antibiotic resistance is increasing to severely high levels throughout the world. The emergence and global spread of new resistance mechanisms threatens our ability to treat common infectious diseases. It is often difficult or impossible to treat infections brought on by bacteria resistant to antibiotics. To prevent the establishment of resistance and increase the usable life of effective antibiotics, it is crucial to use antibiotics responsibly in the medical field, in agriculture, and in animal health.
I want to thank my family from the bottom of my heart, particularly my spouse, my supervisor, and my co-supervisor, for helping me to prepare the manuscript.
© 2025, Mamun Al Asad. This is an open access article distributed under the terms of the Creative Commons Attribution License , which permits unrestricted use, distribution, and build upon your work non-commercially.
a Creative Commons Attribution 4.0 International License. Based on a work at www.crimsonpublishers.com.
Best viewed in